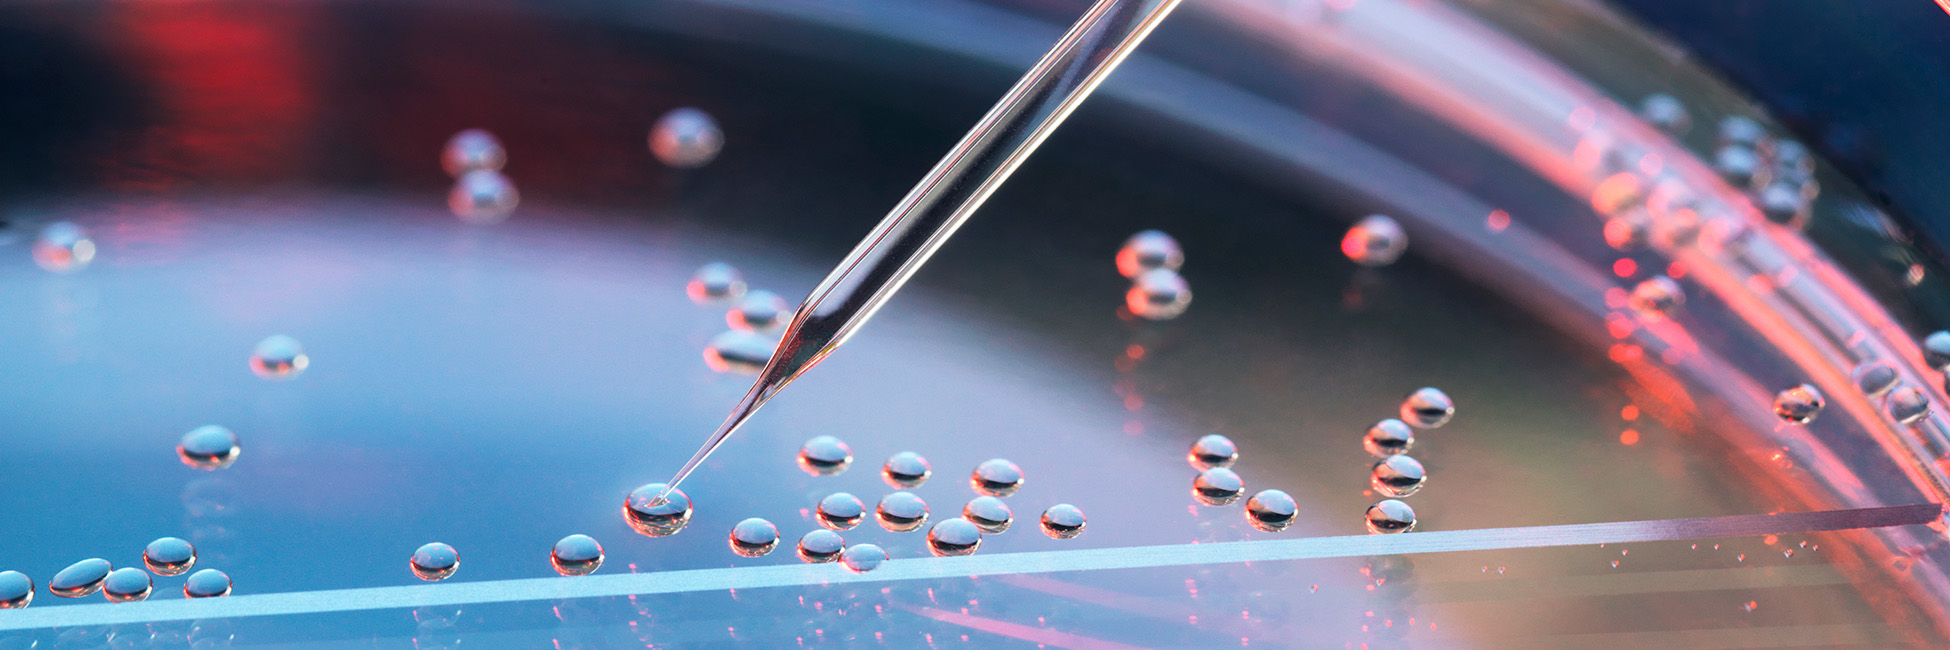

M&A Report
En Bref
- Both deal value and volume dropped in 2022 as companies across the industry paused their M&A activity amid market uncertainty.
- For the first three quarters of 2022, deal activity varied by sector, with pharma, payer, and medtech all seeing large drops in total deal value, while deal value in the provider sector was up slightly.
- We believe that two megadeals in the fourth quarter will be a harbinger of increased healthcare dealmaking to drive growth in 2023.
- We expect pharma M&A activity to rebound quickly as companies look to fill the potential growth gap from the $100 billion in patents set to expire by 2030.
- The equity and debt markets will inevitably stabilize, and the top 25 pharma, medtech, and payer companies all have cash on hand.
This article is part of Bain's 2023 M&A Report.
As the year 2022 drew to a close, the number of strategic healthcare deals had declined by more than 30% and the average deal size had fallen by around 15%. In line with the overall corporate M&A market, it was largely a wait-and-see year. Then, two megadeals announced in the fourth quarter—namely, Johnson & Johnson’s $16.6 billion acquisition of Abiomed in November and Amgen’s $28 billion acquisition of Horizon in December—foreshadowed the possibility of a resumption in robust deal activity.
The long-term underlying drivers of M&A in healthcare remain strong. Across all the industry’s sectors, 1 percentage point of growth (either organic or inorganic) has an average of four times as much impact on total shareholder return (TSR) as 1 percentage point of EBITDA margin expansion. Cash balances are high, with the top 25 pharma, medtech, and payer companies all having at least 15% of their last 12 months' revenues on hand in the form of cash.
Private equity funds also are sitting on a significant amount of cash. With this level of available cash, it is difficult for us to see a world where M&A values do not return in earnest once the market digests the current moment of uncertainty—even if debt markets have gotten more expensive. The speed and nature of that return, however, will vary by sector and region. We’ll look at each sector separately with a special lens on Europe and Asia, where the situation is most dynamic.
Pharma/biotech
Pfizer and Amgen were the most active pharma companies to rely on M&A to spur growth in 2022. Pfizer’s acquisition of Biohaven Pharmaceuticals boosted its commercialized assets in the neurological and migraine space while its purchase of Global Blood Therapeutics was a doubling down in rare hematology. Amgen’s purchase of ChemoCentryx added to its inflammation and nephrology portfolio, and its pending acquisition of Horizon adds multiple on-market and pipeline assets to drive future growth.
Patent expiry will pressure companies to innovate and possibly spark an increase in acquisitions.
Pfizer and Amgen were clear outliers. Across all pharma companies, deal volume and value dropped by more than 30% in 2022, even after Amgen’s acquisition of Horizon. We expect deal activity to accelerate once companies become comfortable with the macroeconomic uncertainty that overshadowed 2022 and as sellers readjust current valuations. We believe pharma could be the fastest among all healthcare sectors to rebound in terms of deal value. There’s available cash, with the top 25 firms holding a combined $130 billion on their balance sheets, and alternative pathways to liquidity have tightened for biotech start-ups, with IPOs all but drying up.
There’s also the looming issue of patent expiry. Globally, the top 15 drugs coming off patent by 2030 generated more than $100 billion in sales in 2020. That will pressure some companies to innovate more quickly and could spark a possible increase in the number of pharmaceutical companies acquiring to catch up on R&D that was stalled during the earlier days of the pandemic. Companies in Europe will turn to M&A to enter or double down on specialty drugs and rare diseases, to perform earlier phase 2 and phase 3 trials, and to speed up expansion in the US. Some large European pharma companies will rely on divestitures and spin-offs to streamline operations.
In the US, we don’t anticipate that the Inflation Reduction Act will cause substantial headwinds for dealmaking in 2023, although potential buyers should be prepared for more price scrutiny. There is some evidence of both a lengthening of the approval process and a more stringent regulatory review process for US transactions. If both continue, it could add to the cost of transactions and the time to close.
In Japan, the recent government policy to spur aggressive digital adoption in healthcare should result in substantial deal activity. That likely will play out in the form of partnerships with foreign companies in vital areas such as artificial intelligence and new drug development, including anti-cancer drugs.
Chinese biotech firms arguably are ripe for consolidation because of a sharp decline in valuations after the Covid-19 pandemic resulted in overinvestments in the sector and amid recent geopolitical tensions toward the biotech industry. China’s geopolitical uncertainty, as well as intensified regulatory pressure from inside and outside the country, slowed dealmaking in 2022. But M&A could bounce back in 2023 as domestic companies turn to deals to expand overseas, or to buy new technology to update mature product lines, or to expand their portfolios with new products to introduce back to China.
In South Korea, we anticipate continued significant M&A in the biotech space and a return of private equity deals, particularly in the services and provider sectors. While strategic acquirers will account for most of the deal value (especially within pharma and medtech), financial sponsors will continue to add on to existing platforms and acquire new platforms on which to pursue a buy-and-build strategy.
Medtech
Similar to other sectors, total deal volume declined meaningfully in medtech in 2022. Until the Johnson & Johnson acquisition of Abiomed in November, there was a notable lack of the type of category leadership moves that were the impetus for a significant portion of deals between 2012 and 2021. The lack of available debt that began in the second quarter of the year and the high cost of debt made large deals less attractive. Much of the M&A that took place—such as Stryker’s acquisition of Vocera Communications—was designed to provide innovative technologies for future growth rather than add products to existing portfolios. The big Johnson & Johnson-Abiomed deal was a dramatic exception, and we believe it may be a harbinger of deals to come and that medtech M&A should bounce back in 2023 based on strong cash availability and the growth prospects of buying, particularly for category leadership.
In China, in vitro diagnostics players, on the back of continuous Covid-19 testing, are actively seeking M&A opportunities to further strengthen their product offerings and expand their market share. For example, in 2021, Mindray acquired HyTest, a manufacturer of antibodies and antigens used in tests for Covid-19 and other illnesses, for more than $660 million.
Provider and services
The provider and services sector stood out for its resilience. Average transaction value rose from less than $200 million to greater than $250 million based in large part on UnitedHealth’s pending purchase of LHC Group for $5.4 billion and a Remgro-led consortium’s acquisition of Mediclinic International for $4.49 billion. Overall, values grew 5%, and volumes dropped 28%.
While there were no large provider network acquisitions in 2022, the highly fragmented nature of this space meant that there were multiple different investment theses at play. For example, Amazon’s acquisition of One Medical gave Amazon a foothold into primary care and an opening to disrupt that part of the ecosystem. When coupled with CVS’s acquisition of Signify Health, we see the continued blurring of the lines between retail and healthcare. UnitedHealth’s Optum division’s pending acquisition of LHC will add a large home care provider to its existing continuum of care. And a Remgro-led consortium’s acquisition of Mediclinic International was a diversification play of a large shipping company acquiring a hospital operator. Meanwhile, private equity maintained its interest in alternate site provider services, such as Ares Management’s investments in US Heart and Vascular.
In Australia, policy reform is leading to consolidation in home care, a trend that should continue in 2023. Given the benefits of scale in this space, larger potential buyers are likely to be home care specialists looking to scale and other senior care (and related) players, such as residential and retirement care companies seeking synergies and efficiencies. We see substantial activity as participants look for strategic bolt-ons to meet operational and financial needs or to acquire capabilities (such as digital) that will be required for long-term growth.
Consolidation is taking place in Southeast Asia, too. The region is expected to see more action affecting healthcare and hospital facilities as evidenced by Metro Pacific Hospital Holdings’ driving hospital consolidation in the Philippines. Meanwhile, Singapore’s regional healthcare provider, HMI Group, is discussing a potential 30% stake sale.
Given the breadth of investment types and opportunities, M&A in the provider and services space should gain momentum in 2023 on a global basis. Alternate site consolidation will continue and possibly intensify given the number of assets that have been hit hard by the Covid-19 pandemic. Nontraditional players such as Amazon will continue to invest in this space to disrupt and reinvent the healthcare market, particularly in the US. Traditional hospital network consolidation, which has been a good avenue for cost reduction, may suffer, however, from the high cost of debt near term.
Payer
Large M&A activity among payers was almost completely dormant in 2022. Total deal volume was relatively flat, but with no large payer deals announced this year, the average deal size fell meaningfully from 2021. This decline is likely because of the high cost of debt and equity market uncertainty. While the payer sector is typically the most cyclical of healthcare sectors from an M&A perspective, and the one with the fewest number of transactions, we do anticipate one or two larger bets in 2023. The main reason: The top 25 companies have a combined $200 billion on their balance sheets. Given the large absolute size of payers in the US, a payer needs to buy another large company to move the needle on revenue.
The current regulatory environment makes the merger of two similar payers challenging in the US, however, which means payers must look to make acquisitions in large adjacencies or face a tough regulatory approval path. It can be hard for large US payers to find big adjacencies that both fit their strategy and will pass regulatory scrutiny. (It is this “buy big in an adjacency to move the needle” dynamic that has led to the boom-bust M&A cycle in recent years.)
Europe’s providers face particularly strong challenges stemming from the pandemic and inflationary environment, which has had its biggest impact in the cost of salaries and rent. Adding to the concerns, public payers are striving to reduce provider fees. While single-payer systems slowed down activity, the continued cost pressures could make consolidation across provider networks an attractive strategic option.
The top 25 payer companies have a combined $200 billion on their balance sheets.
What does it all mean?
Pharma companies should expect to see increased M&A activity in the near future. Active pharma companies would be well served to proactively identify the therapeutic areas that they believe will generate future growth for their company. They then should look at what strategic capabilities they bring to the table. (Are they the best in the world at commercialization? Are they top tier in label extension? R&D?) They should look at targets that fall within their therapeutic area growth plans and that can take advantage of their own unique capabilities. Targets at the intersection of these two dimensions can warrant a higher multiple, allowing acquirers to lean in on valuations and extract higher value through M&A.
In medtech, 2022 was less about growth than about buying for capabilities that can complement the rest of the value chain. But even if debt remains expensive, there may be a return to using M&A both for innovation and category leadership. The best category leadership acquirers develop business unit–level strategies by call point, identify where M&A can play a role, and develop a proactive strategy for targeting specific companies. The most innovative acquirers look beyond category leadership and ask where growth will come from a decade out. They then place multiple strategic bets via M&A to try to be well positioned to take advantage of that growth.
Provider and services companies will continue to acquire for innovation (whether that’s for dental offices or cardiology), with more activity from unexpected disrupters such as Amazon. We expect this space to continue to see substantial activity given the multitude of different potential deal theses available for varying deal sizes and the significant desire from many corners to experiment with disrupting healthcare in the US.
Payers tend to leverage M&A to drive growth. This often takes the form of payers pursuing M&A transactions that are outside of their traditional markets. Whether that takes the form of payers buying providers or payers going even further afield, we anticipate that cash-rich players will continue to innovate via M&A as they look for growth. The current regulatory environment in the US presents unique challenges in this sector that may lead to a delay in the recovery of deal activity compared with other healthcare sectors.